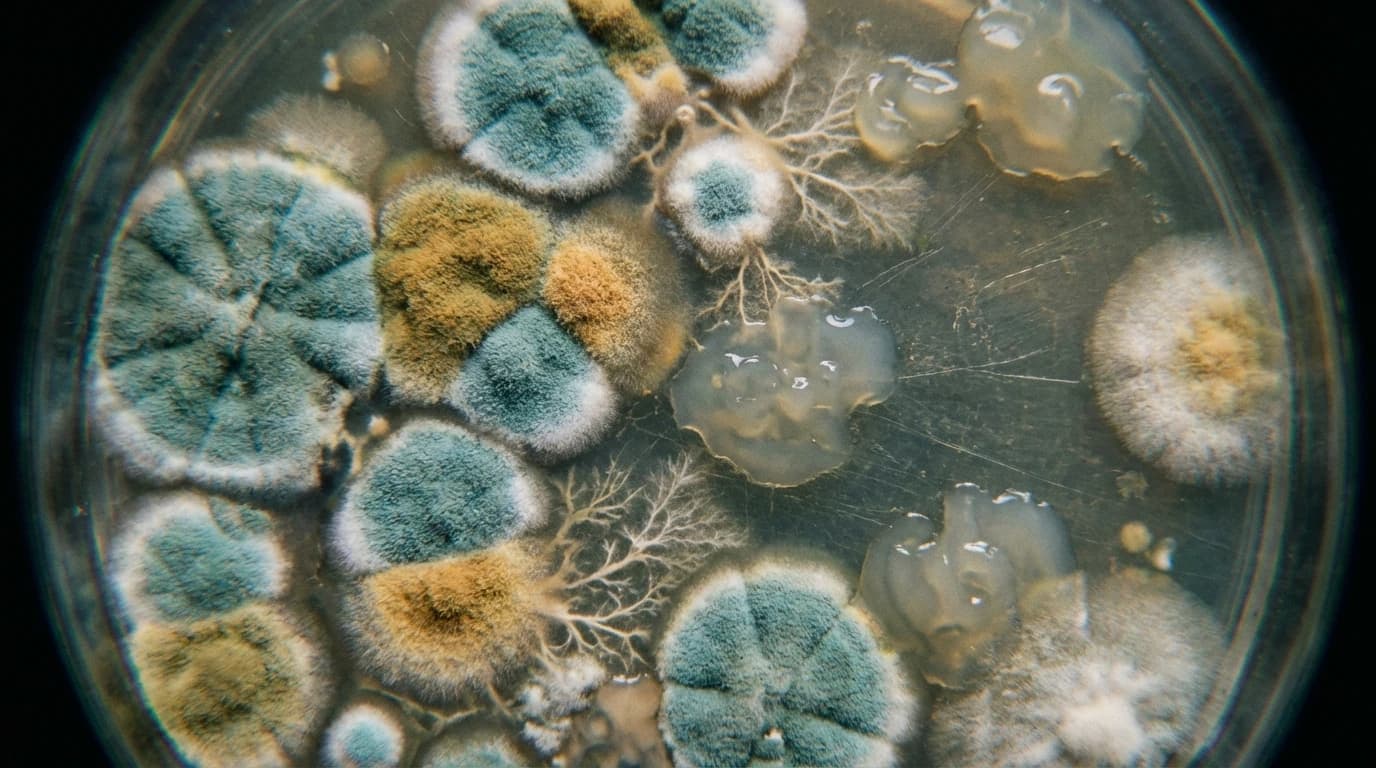
Image for Can AI Master Microbiome Disease Prediction? The Old Maths Still Wins
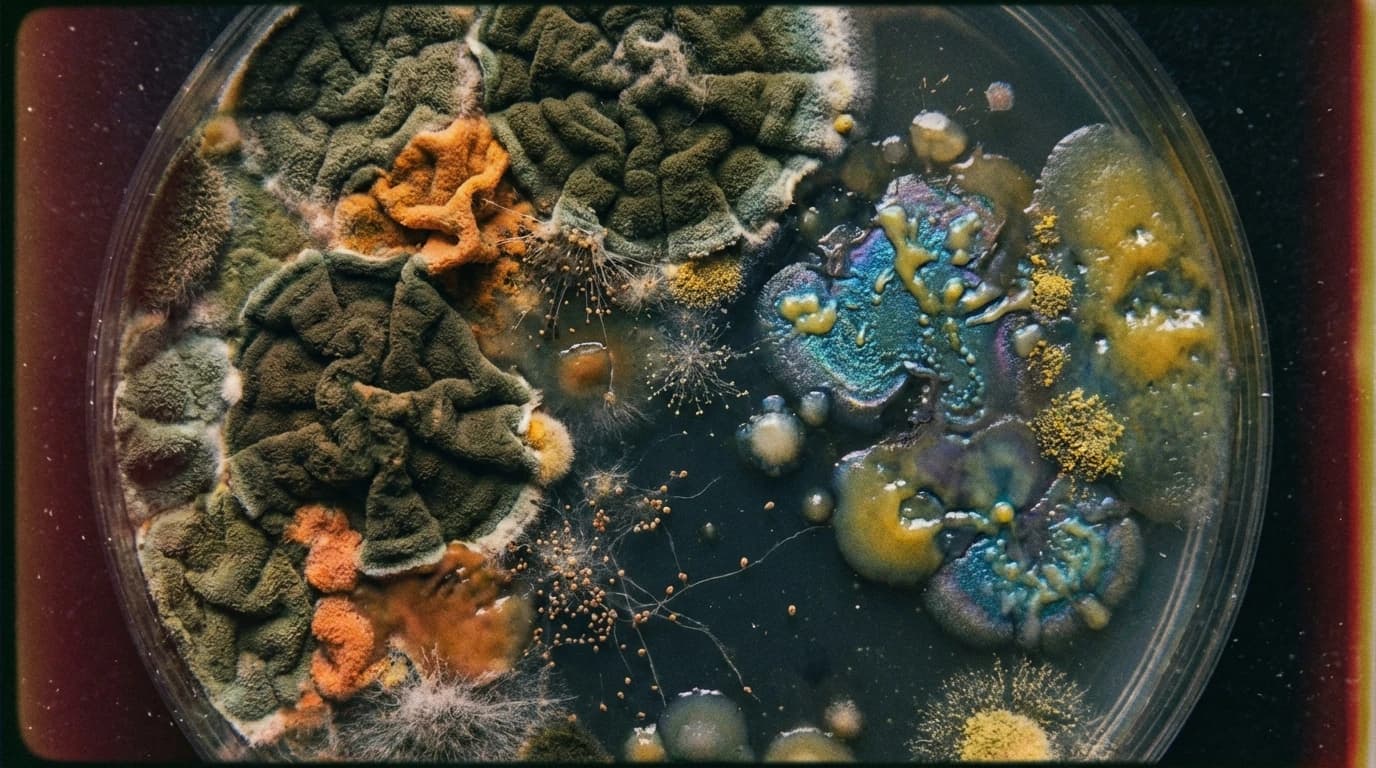
Image for Rethinking Wildlife Disease: The Hidden Role of Microbiome-parasite interactions
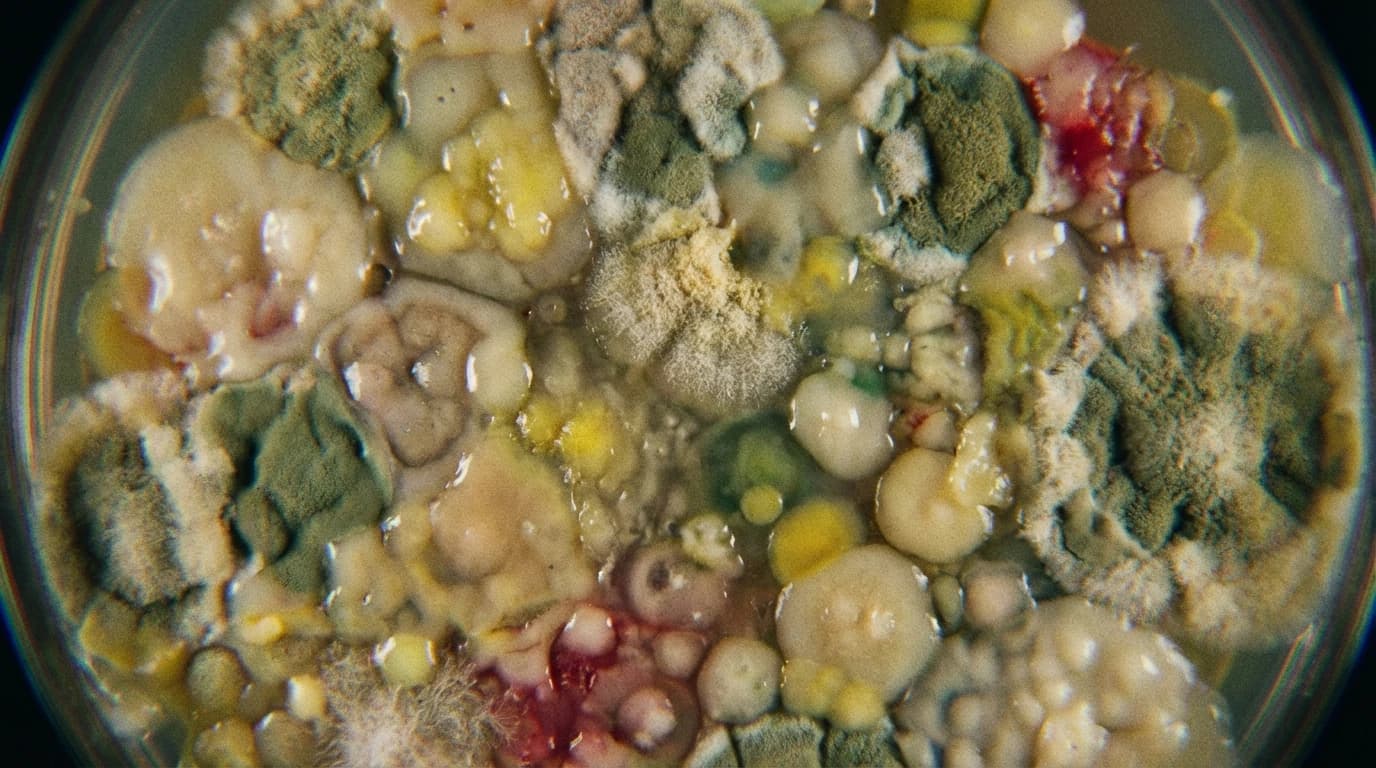
Image for Microbiome disease prediction: Why Classic Algorithms Still Compete with AI
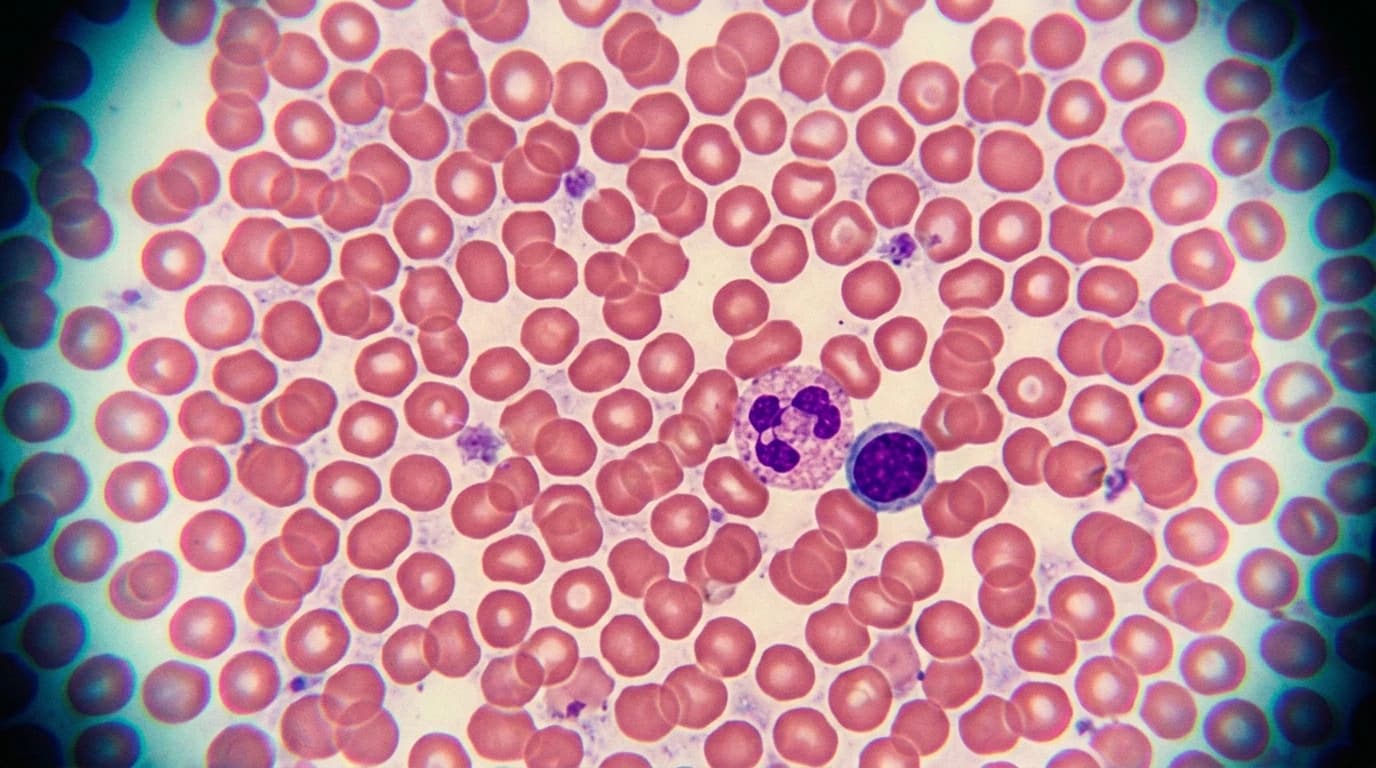
AI vs Parasites: The New Front in Automated Malaria Diagnosis
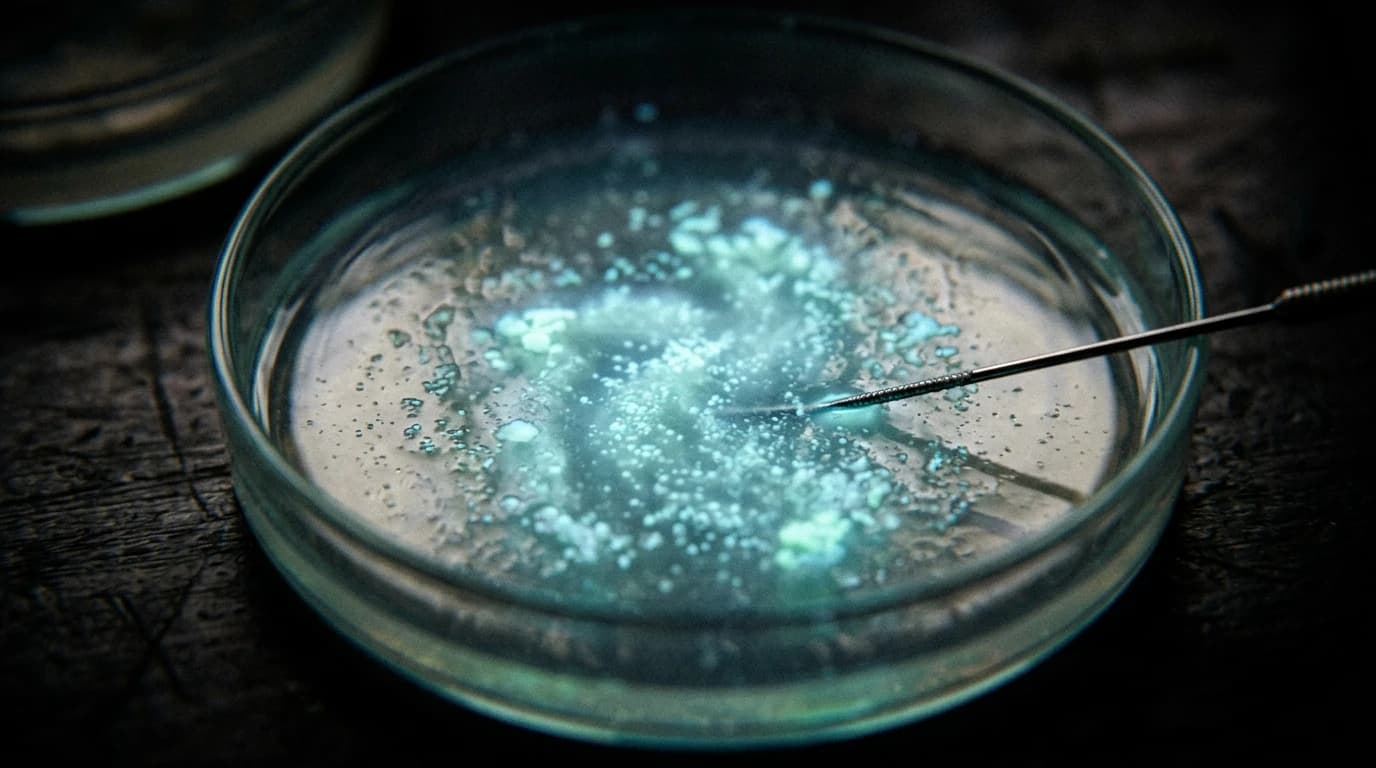
Image for Why the skipjack tuna gut microbiome is the ocean's new weather station
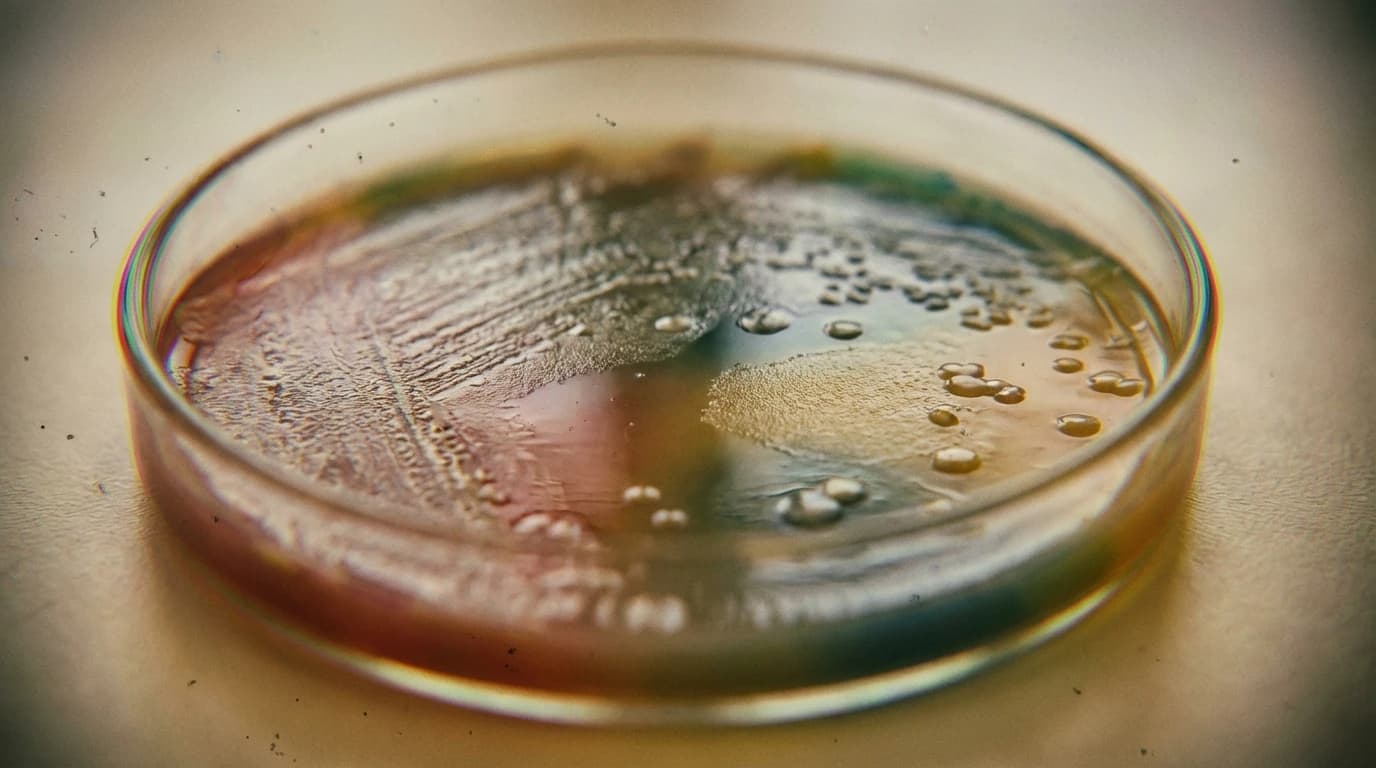
Image for The Rising Threat of MASH in East Asia: Why We Need Better Diagnostic Tools
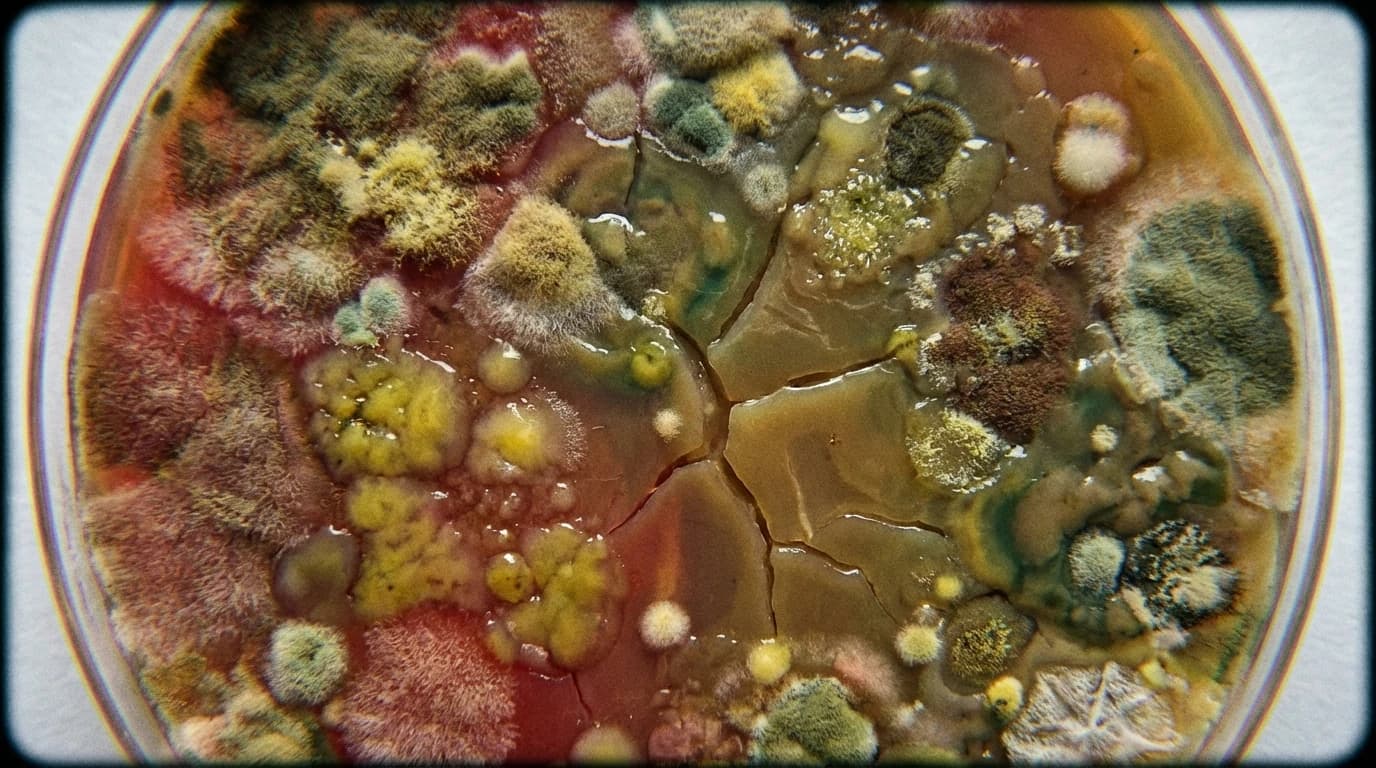
Image for Microbiome disease prediction: Why classic algorithms are still beating advanced AI

Daily Briefing
Friday, 27 February 2026

A Clever Genetic Edit Could Halt Hutchinson-Gilford Progeria Syndrome
Scientists have developed a highly precise, mutation-agnostic genetic editor that removes the 'sticky' trait from toxic proteins causing premature ageing. Early lab tests on tissue organoids show it successfully restores cellular structure and DNA repair mechanisms.
Global Analysis

AI Meets Architecture: A New Approach to Seismic Performance Prediction
Researchers are testing machine learning algorithms to predict how building joints will react during an earthquake. Early-stage research suggests that traditional AI models might outperform complex deep learning in forecasting structural failures.

AI Struggles to Beat Classic Algorithms in Microbiome Disease Prediction
A new large-scale benchmark tests modern AI foundation models against traditional machine learning for detecting diseases from gut bacteria. The early data shows that classical algorithms still hold their ground, suggesting that better data, rather than just newer AI, is required for future progress.

Beyond the Breathalyser: A Scalable New Alcohol Biomarker for Liver Health
Researchers have developed a low-cost screening panel using standard blood tests to detect alcohol-related liver disease. This scalable tool could guide expensive direct testing, making broader liver health monitoring a reality.

Box Office Guesses for Crops: The Smart Tech Behind Wheat Yield Prediction
Researchers have developed a highly accurate AI model that uses non-destructive sensor data to predict wheat harvests. By analysing plant traits like height and greenness, this tool forecasts crop yields better than traditional methods.

Breaking the Nanoscale Bottleneck: The Future of 2D Quantum Sensing
Researchers have directly measured the relaxation time of optical defects in hexagonal boron nitride, solving a longstanding mystery in quantum physics. This precise laboratory data allows for the optimisation of 2D quantum sensors, advancing the groundwork for future high-sensitivity nanoscale measurements.
Can AI Master Microbiome Disease Prediction? The Old Maths Still Wins
A massive new benchmark tests whether advanced AI models can predict human diseases from gut bacteria better than classical machine learning. Surprisingly, the older, simpler algorithms still hold their ground.

Catching Toxic Metals With Glowing Carbon Dots
Scientists are embedding glowing carbon nanomaterials into solid plastics to create cheap, reusable sensors. These composites instantly change colour or dim when they detect toxic heavy metals in water.

Could a New Herbal Treatment for COVID-19 Help Clear the Virus Faster?
Researchers tested a traditional Ayurvedic blend against SARS-CoV-2 using computer models, lab cells, and human trials. The results suggest this herbal formulation acts as a strong complementary defence, significantly speeding up recovery times.

Decoding the Brain's Signals: The Complicated Science of Oxytocin for Weight Loss
Scientists are exploring oxytocin's neuronal system as a potential treatment for obesity, noting its ability to suppress appetite and boost fat burning in preclinical studies. However, heterogeneous clinical results and dosing challenges mean the path to a safe, reliable therapy remains complex.

Direct Measurement of Spin Dynamics Advances 2D Quantum Sensing
Physicists have directly measured the ultra-fast relaxation time of intermediate spin states in hexagonal boron nitride. This exact measurement allows for highly optimised laser pulse sequences, substantially improving the sensitivity of atomic-scale sensors.

Editing the Clock: A New Approach to Hutchinson-Gilford Progeria Syndrome
Scientists have developed a highly specific base-editing tool that prevents toxic proteins from damaging the cellular nucleus. By targeting the protein's attachment site rather than the underlying mutation, this early-stage research offers a potential universal approach for rapid ageing disorders.

Evaluating Optical quantum circuits: A Leaner Approach to High-Dimensional Testing
Physicists have validated a new method for testing optical quantum modules using high-dimensional photon interference. This approach keeps measurement resource demands flat even as system complexity increases, offering a highly efficient alternative to traditional tomography.

Generative AI Redefines the Design Limits of Lattice Metamaterials
Engineers have combined deep learning with voxel-level generation to design highly efficient structures that absorb both impact energy and sound. This method outperforms traditional topology optimisation, offering a rigorous new approach to complex structural design.

How Lactylation in Cancer Could Rewrite the Next Decade of Oncology
For years, scientists struggled to understand how cellular waste products fuel tumour growth. A recent review details how lactylation directly links metabolism to gene regulation, offering entirely new targets for therapies over the next decade.

How machine learning for seismic performance prediction could reshape structural engineering
Engineers are testing AI models to predict how flat plate buildings will react to earthquakes. Early findings suggest specific algorithms can accurately forecast structural stress, offering a faster way to design safer cities.

How Transgene-Free CRISPR Plant Breeding Could Overhaul Global Agriculture
Traditional crop improvement is slow and tangled in strict GMO regulations. A new review highlights how transgene-free CRISPR methods bypass these hurdles by editing native genes without introducing foreign DNA, promising a faster, regulation-friendly route to enhanced crops.

Mapping Methylphenidate Brain Effects: How ADHD Drugs Alter Male and Female Synapses Differently
A recent laboratory study demonstrates that clinically relevant doses of methylphenidate alter synaptic structural proteins differently in male and female brains. The findings expose significant flaws in older pharmacological models that failed to separate subjects by biological sex.

Regenerative medicine for brain injury: Why new neurons need a support crew
Implanting bare neurons into a damaged brain often fails because the cells struggle to survive. A new lab study shows that packaging them with support cells called astrocytes helps them thrive, wire up, and heal damaged tissue.

Soft grippers gain the sense of touch: AI and smart materials shape the trajectory of robotics
Researchers have developed self-powered soft robotic hands that use contact electricity and machine learning to accurately identify objects. This advancement overcomes traditional sensor vulnerabilities, offering a reliable way for robots to 'feel' materials despite environmental interference.

Targeting Malignant Synapses to Prevent Glioblastoma Recurrence
Researchers have discovered that glioblastoma cells secrete a specific protein to force healthy neurons into building malignant networks. By applying a novel inhibitor, scientists successfully blocked this physical integration in the laboratory, offering a new structural approach to treating aggressive brain tumours.

The Future of the Biden Clean Energy Policy: Why Local Governors Are Getting the Credit
The federal government is funding massive climate infrastructure, but local voters are crediting their state governors instead. This observational study suggests that fragmented communication limits the political returns of national green investments.

The Future of Trail management: How a Standardised Vocabulary Will Protect Our Parks
Researchers have mapped out the confusing terminology used across ecology and recreation science. By standardising these terms, they created a decision-making flowchart to help conservationists protect biodiversity while keeping nature accessible.

The Ghost in the Machine's Eye: The Science of Point Cloud Completion
As autonomous systems increasingly rely on 3D scanning, they frequently encounter missing data due to real-world obstacles. A new comprehensive survey evaluates the latest deep learning methods designed to help machines mathematically guess and reconstruct these missing physical shapes.
The Next Decade of Advanced Prostate Cancer Clinical Trials: A Data-Driven Framework
An international expert committee has updated the standard criteria for clinical trial design in prostate oncology. By modernising imaging and biomarker definitions, this framework aims to optimise therapy development and refine precision medicine.